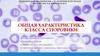
Общая характеристика Класса Споровики

Similar presentations:
Общая характеристика кокцидий. Еймериозы
1.
Общая характеристика кокцидий.Еймериозы.
2.
ЛитератураХейсин Е. М. «Жизненные циклы кокцидий
домашних животных», Наука, 1967.
Бейер Т.В. и др. Цитология кокцидий. Наука,
1978.
Крылов
М.В.
Возбудители
протозойных
болезней домашних животных и человека (в двух
томах).С.-П., ЗИН РАН, 1994.
Крылов М.В. Определитель паразитических
простейших. С.-П., Наука, 1996.
Руководство
по
зоологии.
2
том
Протистология.
Раздел
Споровики.
Под
редакцией акад. Алимова, 2005.
3.
ОпределениеКокцидиидозы – это остро, подостро и
хронически протекающие протозойные болезни
продуктивных,
домашних
и
диких
млекопитающих (в т.ч. человека), а также птиц,
земноводных, рептилий и т.д., вызываемые
представителями
отряда
Cocciidiida,которые
проявляются общим угнетением, поражением
эпителиальных клеток кишечника и
других
органов, расстройством пищеварения (диареей),
прогрессивным исхуданием и массовой гибелью
молодняка.
Для большинства кокцидий характерна
специфичность и внутриклеточный паразитизм в
различных органах и тканях.
4.
Экономический ущерб при кокцидиидозахскладывается из:
•снижения привесов;
• снижения продуктивности;
• падежа и вынужденного убой больных животных и птиц;
•дополнительных затрат на увеличение расхода кормов;
• дополнительных затрат на проведение лечебнопрофилактических мероприятий.
5.
История описанияО существовании кокцидий стало известно
благодаря работам Антони ван Левингука (Antonio van
Leeuwenhoek), обнаружившего в 1674 году в желчном
пузыре кролика ооцисты Eimeria stiedai. Большое число
видов кокцидий из различных групп животных описал
Эймер (Eimer, 1870).
За рубежом за последние 50 лет появилось
несколько крупных монографий, в которых освещаются
перечисленные выше вопросы изучения кокцидии. Среди
них следует упомянуть монографии Ливайна и Ливайна и
Ивенс (Levine, 1961; Levine, Ivens, 1965, 1970), важную
обобщающую работу по видовому составу кокцидии —
«Кокцидии и кокцидиозы» Пеллерди (Pellerdy, 1974).
В последнее время появились прекрасные обзоры
по Мировой фауне кокцидий (Duszynski e.a., 2000).
6.
Внашей
стране
–
это
многочисленные
исследования
В. Л. Якимова, обобщенные в его
известной книге «Протозойные болезни домашних
животных»
(1931).
Многочисленные
работы
по
кокцидиозам домашних животных выполнены Н. А.
Колабским и его сотрудниками (Колабский, Пашкин,
1974), Е. М. Хейсиным и его ученикми, в частности М.В.
Крыловым. Работы Е. М. Хейсина в этом направлении и в
особенности монография «Жизненные циклы кокцидий
домашних животных», переведенная на английский язык
и изданная в США, могут по праву считаться
классическими.
7.
Систематическое положение кокцидийЦарство Protozoa
Тип Apicomplexa
Класс Sporosoa
Отряд Coccidiida
Семейство Eimeriidae
Род Eimeria
моноксенные паразиты
Род Isospora
Род Cystoisipora - факультативно гетероксенные
Cемейство Sarcocystidae
П/семейство Toxoplasmatinae
Род Toxoplasma – факультативно-гетероксенные паразиты
Род Besnoitia
Род Neospora
- гетероксенные паразиты
П/семейство Sarcocystinae
Род Sarcocystis
Семейство Cryptosporidiidae
Род Cryptosporidium – моноксенные паразиты
8.
Жизненные циклы кокцидий.Общая характеристика.
9.
Специфичность кокцидий в зависимости от стадииразвития и локализации
Одно из наиболее интересных явлений в
паразитологии – существование у паразитических
организмов приспособленности к определенному виду
или
группе
видов
хозяев
–
специфичности.
Специфичность проявляется в виде приуроченности
паразита к хозяину.
Многочисленные эксперименты по заражению
хозяев показали, что для кокцидий характерна в
большинстве случаев узкая специфичность.
10. Локализация эймерий в кишечнике кур
Эймерии относятся кспецифическим
паразитам не только по
виду хозяина, но и по
месту локализации их в
организме хозяина.
Последнее
обстоятельство
обеспечивает
одновременное
паразитирование
нескольких видов
кокцидий в организме
птиц
11. Продолжительность инвазии
Продолжительностью кокцидиозной инвазии называют весь периодвремени от момента заражения животных ооцистами кокцидий до
полного освобождения их от этих паразитов. Многие исследователи
делят ее на два периода: препатентный, который длится с момента
заражения животных возбудителями кокцидиозов до появления
ооцист в их фекалиях, и патентный период – с момента появления
ооцист до окончательного исчезновения их из организма животного.
Длительность этих периодов зависит от продолжительности
эндогенного развития кокцидий. Эндогенное развитие кокцидий при
однократном заражении свободных от кокцидий животных может
заканчиваться в определенный, для каждого вида, срок, и в таких
случаях инвазия прекращается. По данным Е. М. Хейсина, при
заражении кроликов ооцистами Е. magna инвазия длится около 25
дней, с колебаниями в 2-3 дня, Е. irresidua – 18-24 дня, Е. piriformis –
17-22 дня, Е. media – 12-14 дней и Е. perforans – 11-13 дней.
12.
Для большинства кокцидий характерно чередование поколений.Различные формы агамного размножения, способствующие увеличению
плодовитости, сменяются половым процессом. У части кокцидий, наряду с
агамным размножением, увеличивающим продуктивность, в жизненный
цикл включается смена хозяев. У всех моноксенных и части гетероксенных
кокцидий в жизненном цикле присутствуют стадии, развивающиеся в теле
хозяина – меронты и гамонты (эндогенные) и стадии расселения – ооцисты,
спороцисты, спорозоиты, находящиеся вне организма хозяина (экзогенные).
Стадия, заражающая хозяина – спорозоит. Спорозоит, проникнув в
клетку или ткань хозяина, превращается в трофозоит, который по мере
роста и деления ядра трансформируется в многоядерную особь – меронт,
меронт делится на мерозоиты, число которых обычно равно числу ядер в
меронте. Число мерозоитов, продуцируемых одним меронтом, широко
варьируется от единиц до десятков тысяч. Мерозоиты могут вновь
проникать в клетки хозяина и снова превращаться в многоядерные стадии –
меронты с последующим образованием мерозоитов. Такой способ
размножения может повторяться несколько раз, способствуя накоплению
паразитов в организме хозяина и
называется мерогонией. Агамное
размножение сменяется половым процессом. Мерозоиты превращаются в
макро- и микрогамонты. Микрогамонты продуцируют обычно много
микрогамет, макрогамонт – одну макрогамету. Половой процесс (гаметогония)
завершается образованием инцистированной зиготы, которая называется
ооцистой.
13. Жизненный цикл рода Eimeria
Увсех
кокцидиид
зигота
претерпевает
спорогонию,
заканчивающуюся
формированием
спорозоитов,
число которых варьируется в
зависимости
от
рода.
Формированием
ооцист
завершается эндогенное развитие
кокцидий.
Выделившиеся
во
внешнюю
среду
ооцисты
в
большинстве
случаев
неспорулированные,
кроме
представителей родов Sarcocystis
и Cryptosporidium, у которых
спорогония
происходит
в
организме хозяина, и во внешнюю
среду
выделяются
спорулированные ооцисты.
14.
Практика животноводческих хозяйств показывает, чтококцидиидозная инвазия бывает очень длительной, и
ооцисты кокцидий выделяются беспрерывно при
заболевании молодняка птиц, кроликов, крупного рогатого
скота.
Хроническое
течение
кокцидиидозов
обусловливается
постоянной
реинвазией,
а
не
длительностью эндогенных стадий развития возбудителя.
Срок образования ооцист зависит от продолжительности
каждой генерации мерогонии, а также от того, через какой
промежуток времени и какая генерация мерозоитов
переходит на путь гаметогонии. Длительность развития
эндогенных стадий зависит от физиологического
состояния животного, от условий содержания его и
кормления, а также от дозы инвазионного материала и
целого ряда других причин. Все эти факторы безусловно
влияют и на длительность кокцидиозной инвазии.
15. Иммунитет
Иммунитет при кокцидиозах нестерильный и при отсутствииреинвазии, непродолжительный – 50-60 дней. Напряженность
зависит от иммуногенности вида кокцидий, дозы и кратности
заражения. У взрослых животных и птиц сформированный
иммунитет поддерживается за счет постоянной реинвазии.
Многие исследователи занимались вопросами иммунитета и
на примере птиц показали, что иммунитет у птиц возникает только
после перенесения ими повторных инвазий, и иммунитет при
кокцидиозе птиц возможен только к тому виду возбудителя,
который вызвал первичную болезнь. Поэтому кокцидиозный
иммунитет подразделяется по напряженности на две степени.
Первая возникает при заражении небольшим количеством
паразитов, при этом создается слабый иммунитет, и при заражении
суперлетальными дозами у них развивается повторное заболевание.
Вторая степень иммунитета развивается при заражении птиц
большими дозами кокцидий, в этом случае после переболевания
животные становятся невосприимчивыми к повторному заражению.
16.
Может!Может ли быть
бессимптомное
течение
болезни?
У взрослых (переболевших)
иммунных животных или при
слабом заражении, когда в
организм попадает
небольшое количество
эймерий. Поэтому паразит
может находиться
неопределенно длительное
время в хозяйстве –
кокцидионосительство. У
каждого паразита срок
пребывания в организме
животного строго
определенный и если
провести ряд
профилактических
мероприятий, то возможно
естественное
выздоровленение.
17. Патогенез
После проникновения расселительных стадий (спорозоитов) в эпителиальныеклетки кишечника, а у кроликов, кроме кишечника, и в эпителиальные клетки
желчных протоков печени, происходит эндогенный цикл развития.
В слизистой оболочке кишечника паразиты размножаются путем мерогонии
и вызывают массовую гибель эпителиальных клеток. Установлено, что одно
больное кокцидиозом животное выделяет во внешнюю среду ежедневно от 9
до 980 млн. ооцист кокцидий. А это означает, что в организме больного
животного ежедневно гибнет более 500 млн. эпителиальных клеток
кишечника. Разрушаются не только клетки, в которых размножаются
паразиты, но и соседние с ними клетки, капилляры и сосуды. При таком
массовом распаде клеточных элементов хозяина нарушается целостность
стенки кишечника. В ее пораженные участки проникает микрофлора, которая
обостряет течение болезни, вызывая обширные некрозы слизистой оболочки.
В связи с этим целые отрезки кишечника не участвуют в пищеварении. Все
это приводит к хроническому голоданию организма животного, к застойным
явлениям и отекам в различных органах и тканях. Возникшие патологические
процессы выражаются гидремией, лейкопенией, замедлением пульса и частым
мочевыделением.
18.
Массовое размножение кокцидий в слизистойкишечника и распад ее клеточных элементов приводит к
тому, что на мертвом белковом субстрате размножается
гнилостная микрофлора. Она еще больше осложняет
воспалительные процессы в кишечнике, вызывает
расстройство его всасывательной и двигательной
функций, способствует развитию диареи. В результате
усиливающихся воспалительных процессов происходит
выпот экссудата в просвет кишечника, который,
затрудняет всасывание жидкости в организме животного
и создает отрицательный водный баланс, значение
которого в патогенезе кокцидиоза очень велико. Потеря
больным организмом 10—15% воды нарушает водный
баланс, что приводит к увеличению вязкости крови, а
последнее осложняет работу сердца.
19.
Морфологические и биохимические исследованиякрови показывают, что при кокцидиозах уменьшается
количество эритроцитов и гемоглобина, развивается
анемия. Кроме того, в период острого течения болезни
снижаются содержание сахара в крови, глютатиона,
каталазы и резервной щелочи.
Патогенез
кокцидиидозов
дает
основание
рассматривать их как болезнь всего организма, а не только
того органа, в котором паразитирует тот или иной вид
возбудителя. Исходя из этого, при лечении больных
наряду с введением кокцидиостатических препаратов,
необходимо применять целый ряд симптоматических
лекарственных веществ.
20. Морфология
21. Схема строения ооцисты кокцидий рода Eimeria (эймериоидный тип споруляции)
а – неспорулировавшаяооциста; б – спорулировавшая
ооциста. 1 – микропилярная
шапочка; 2 – наружный слой
стенки ооцисты; 3 –
внутренний слой стенки
ооцисты; 4 – микропиле; 5 –
светопреломляющая гранула;
6 – зигота; 7 – остаточное тело
в ооцисте; 8 – спороциста; 9 –
штидовское тельце; 10 –
спорозоит; 11 –
светопреломляющее тело в
спороцисте; 12 – остаточное
тело в спороцисте ( по:
Крылов, 1994).
22. Ооцисты эймерий
Род Eimeriaнеспорулированная
ооциста
Род Eimeria
спорулированная ооциста
23. Изоспороидный тип споруляции у родов Isospora, Cystoisospora, Toxoplasma, Neospora, Besnoitia, Sarcocystis
Ооцисты Toxoplasma gondiiпод световым микроскопом.
Cystoisispora felis
неспорулированая ооциста
(слева); спорулированная
ооциста (справа)
24. Eimeria maxima: спорозоит покидает спороцисту
25. Мерогония (бесполое размножение)
Спорулированная(зрелая) ооциста
с
кормом
или
водой
попадает в
кишечник
специфического хозяина.
Спорозоиты
(8
штук)
выходят из ооцисты и
проникают
в
эпителиальные
клетки
слизистой
оболочки
кишечника,
трансформируются в трофозоиты,
делятся, увеличиваются в
объеме и превращаются
в меронты.
Eimeria tenella:
мерозоиты и меронты
26.
Eimeria tenella:мерозоиты
Ядро каждого меронта
множественно делится и
образует многоядерную
клетку – меронт первой
генерации. Внутри такого
меронта формируются
мерозоиты, с их
образованием разрушается
эпителиальный слой
слизистой оболочки
кишечника. Мерозоиты
выходят, и вновь проникают в
эпителиальные клетки
кишечника. Стадия мерогонии
может повторяться несколько
раз (до образования 2-3
генераций).
27. Гаметогония
Мерозоиты последней генерации меронтов проникют вклетки хозяина и превращаются в одноядерные трофозоиты. Из них в дальнейшем формируются макро- и микрогамонты.
Макрогамонты
превращаются в малоподвижные крупные макрогаметы –
женские половые клетки, а из
микрогамонтов
образуются
микрогаметы – мелкие серповидные мужские клетки с
двумя жгутиками. Затем они
сливаются и образуют зиготу.
Зиготы покрываются оболочками и превращаются в ооцисты.
Гаметогония
Eimeria tenella:
микрогаметоциты и макрогамета
28.
29. Ооцисты неспорулированные спорулированные
30. Репродуктивная способность кокцидий
Заражение цыплятодной ооцистой
Количество
ооцист,
выделенные за
патентный период
с пометом
Eimeria tenella
E. acervulina
От 400 тыс. до 2.5
млн.
72 тыс.
E. necatrix
58 тыс.
E. maxima
12 тыс.
31. Эймерии кроликов
32. Эймериозы птиц
33. Виды кокцидий рода Eimeria, паразитирующие у кур
Eimerianecatrix
Eimeria
tenella
Eimeria
mitis
Gallus gallus
Eimeria
brunetti
Eimeria
acervulina
Eimeria
maxima
34. Эпизоотологические данные
Распространены повсеместно. Это связано сбольшой устойчивостью ооцист к факторам
внешней среды и дезинфектантам, высокой
репродуктивной способностью паразита,
сложным и непродолжительным циклом
развития. Болеет молодняк всех видов птиц.
Источники – больные и переболевшие и
носители (взрослые) птицы, загрязненные
корм и вода. Болезнь носит сезонный
характер, но при нарушении содержания –
скученность, плохое кормление,
антисанитария - может регистрироваться в
любое время года.
35. Причины
Большое значение враспространении эймериоза
имеют нарушения
ветеринарно-зоотехнических
требований:
• скученное содержание;
• повышенная влажность в
птичниках;
• неполноценное
кормление;
• нарушение технологии
выращивания.
36. Клинические признаки
Инкубационный период колеблется от 2 до 3 недель.В начале болезни сильнейшее угнетение, снижение
подвижности, птицы стремятся к теплу, снижается аппетит.
На 2-3 день появляется расстройство пищеварения
(диарея), нарушение всасывания. При разрушении
эпителиальных клеток, разрушаются и мелкие кровеносные
сосуды, поэтому в помете птиц обнаруживают прожилки
крови и как следствие – развивается анемия.
При нарушении всасываемости в кишечнике повышается
вязкость крови, что приводит к тахикардии и различным
изменениям в формуле крови. Развивается жажда.
На слизистой оболочке с разрушением эпителия
нарушается целостность стенки кишечника и на мертвом
белковом субстрате размножается гнилостная
микрофлора, что приводит к некрозам, накапливаются
токсины, которые при всасывании вызывают парезы и
параличи.
37. Патологоанатомические изменения
Трупы птиц истощены, видимые слизистыеоболочки
анемичны,
наблюдается
катаральное
воспаление. В области клоаки перьевой покров
загрязнен жидкими фекальными массами. На отдельных
участках слизистой оболочки тонкого кишечника видны
эрозии и язвы. Иногда в толще слизистой толстого
отдела кишечника обнаруживают узелки белого цвета, в
которых находят возбудителей на разных стадиях
развития. При тяжелом течении болезни отмечают
геморрагический энтероколит. Печень приобретает
мраморный рисунок, иногда в печени обнаруживают
участки некроза.
38.
Патологоанатомические изменения приэймериозе
39. Eimeria tenella
Поражениеслепых
отростков
кишечника
E. tenella
Патологические
изменения,
вызванные
E. tenella
Интенсивная
степень
инвазии
E.tenella
40. Поражения переднего и среднего отдел кишечника
E.acervulinaE.necatrix
E.maxima
41.
Благодаримза внимание!
Вопросы?










































 biology
biology